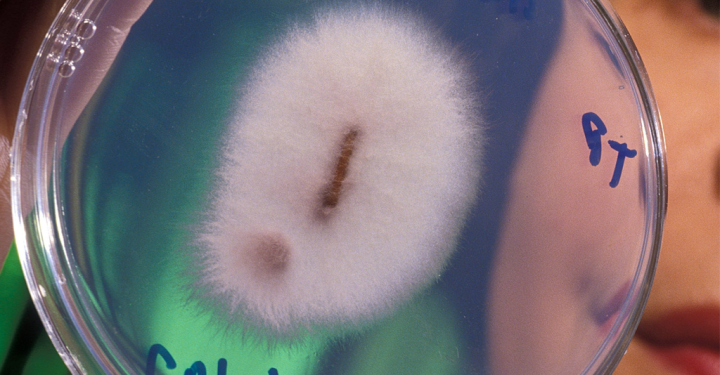
Fim da pobreza? Fungo que transformam mineiras em ouro puro foi descoberto e pode ser cultivado em casa

Entre as recentes descobertas científicas, o fungo Fusarium oxysporum ganhou destaque por sua capacidade de transformar minerais do solo em pequenas quantidades de ouro.
Cientistas da Commonwealth Scientific and Industrial Research Organisation (CSIRO), na Austrália, anunciaram essa capacidade peculiar do fungo em um estudo publicado em 2024.
Este descobrimento chamou a atenção de pesquisadores de diversas áreas devido ao seu potencial para transformar práticas mineradoras e contribuir para soluções mais sustentáveis.
O segredo do ouro no jardim
Localizado predominantemente na região rica em minas de Boddington, na Austrália Ocidental, o Fusarium oxysporum opera de forma única. Ele absorve minerais como ferro e cálcio e, através de reações bioquímicas, converte essas substâncias em nanopartículas de ouro.
Este fenômeno é categorizado como um ciclo biogeoquímico e destaca-se por não demandar processos industriais poluentes, surgindo como uma alternativa menos agressiva ao meio ambiente em comparação à extração tradicional de ouro.
Produção de ouro pelo fungo
O processo de metamorfose do Fusarium oxysporum não só oferece uma alternativa à mineração convencional, mas também abre caminho para novas abordagens no campo da biotecnologia.
As reações bioquímicas realizadas pelo fungo ocorrem em condições controladas, transformando íons de ouro em partículas sólidas que se acumulam na superfície do micro-organismo.
Assim, apesar de a produção ser em escala microscópica, ela estabelece um novo paradigma para a extração de metais preciosos de forma sustentável.
Potencial científico e econômico
Cientistas têm investigado a possibilidade de expandir o uso deste fungo além do laboratório. A capacidade de cultivar Fusarium oxysporum em ambientes domésticos desperta interesse tanto na comunidade acadêmica quanto entre entusiastas.
Embora necessite de cuidados específicos, como a manutenção de um ambiente úmido e temperatura entre 20°C e 28°C, ele pode ser cultivado com kits científicos disponíveis no mercado. A prática, ainda experimental, permite explorar as possibilidades do fungo em pequenas escalas, destacando seu potencial biotecnológico.
Riscos e desafios para a mineração sustentável
A habilidade do Fusarium oxysporum de produzir ouro não está isenta de desafios. O volume atual de produção é insuficiente para substituir práticas industriais, e o processo depende de condições específicas laboratoriais.
No entanto, há grande interesse no desenvolvimento de métodos de mineração que utilizem a biotecnologia para reduzir o impacto ambiental. A ideia de empregar micro-organismos para este fim, conhecida como mineração metabólica, é uma esperança para um futuro mais sustentável.